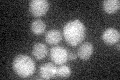
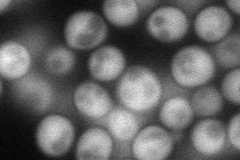
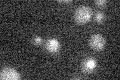

View description
Mitochondrial intermembrane space protein that functions in mitochondrial copper homeostasis, essential for functional cytochrome oxidase expression; homologous to Cox17p; contains twin cysteine-x9-cysteine motifs
Localization:
Intensity:
Fold change:
Significance:
-
C’ GFP library in SD
below threshold16.46 -
N' NOP1pr-GFP in SD
cytosol71.5443 -
N' TEF2pr-mCherry in SD

cell periphery,vacuole0 -
N' NATIVEpr-GFP in SD

below threshold20.6461 -
N' TEF2pr-VC and Cyto-VN in SD

mitochondria34.1596 -
C’ GFP library in SD+DTT

cytosol16.681.01No -
C’ GFP library in SD+H2O2

cytosol15.550.94No -
C’ GFP library in Starvation Media
cytosol13.790.83No -
C’ GFP library on the background of Pup2-DaMP

below threshold -
C’ GFP library on the background of CCT mutant

below threshold16.19780.983626No
